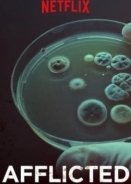
Afflicted (2018)

Jonathan Strange and Mr Norrell (2015) TV Series
05 окт 2015
Προστέθηκαν όλα τα επεισόδια (Σύνολο επεισοδίων 7)
«Η σειρά εξελίσσεται στις αρχές του 19ου αιώνα, μια εποχή όπου η Αγγλία δεν πιστεύει πλέον στην μαγεία. Ο μοναχικός Mr Norrell του Hurtfew Abbey προκαλεί το δέος στην πόλη του York, οταν προκαλεί την κίνηση και την ομιλία των αγάλματων του Καθεδρικού Ναού. Με λίγη πίεση και βοήθεια απο τον φίλο του Childermass, ο Norrell πηγαίνει στο Λονδίνο για να βοηθήσει την κυβέρνηση στον πόλεμο ενάντια στον Ναπολέων. Εκεί στο Λονδίνο, o Norrell θα προσπαθήσει να φέρει πίσω απο τους νεκρούς την Lady Pole, ανοίγοντας έτσι την πόρτα της κολάσεως.»
- moomza: 3.2
- imdb:
- Χωρα:
- Σκηνοθεσία:
- Πρωταγωνιστούν:
- Είδος: Ολοκληρωμένες Σειρές / Σειρές
Ταινία Jonathan Strange and Mr Norrell (2015) TV Series online greek subtitles
Προβολές: 7 844
- Player #1
- Trailer
Jonathan Strange and Mr Norrell (2015) TV Series
Ταινία 2015 online με ελληνικούς υποτίτλους
Το συναίσθημα της ταινίας Jonathan Strange and Mr Norrell (2015) TV Series
-
Smile0
-
Happy0
-
Love0
-
Embarrassed0
-
Shocked0
-
Sad0
-
laugh0
-
Excited0
-
Cry0
-
Kiss0
-
Cool0
-
Neutral0
-
Devil0
-
Silly0
Μην χάσετε!
2016 •
- Σκηνοθεσία:
- Πρωταγωνιστούν:
Ολόκληρη η 1,2η Σεζόν Ένας Βρετανός εκφωνητής σε έναν ραδιοτηλεοπτικό σταθμό στο Λος Άντζελες μεθάει και καταλήγει στην φυλακή, και έτσι καταλήγει να "παλεύει" για την σωτηρία της εκπομπής του....
Online

Online
Cleaners (2013-2014) TV Series
•
Σειρές / Ολοκληρωμένες Σειρές
Κριτικές για την ταινία Jonathan Strange and Mr Norrell (2015) TV Series (3)
Информация
Посетители, находящиеся в группе Гости, не могут оставлять комментарии к данной публикации.
Посетители, находящиеся в группе Гости, не могут оставлять комментарии к данной публикации.